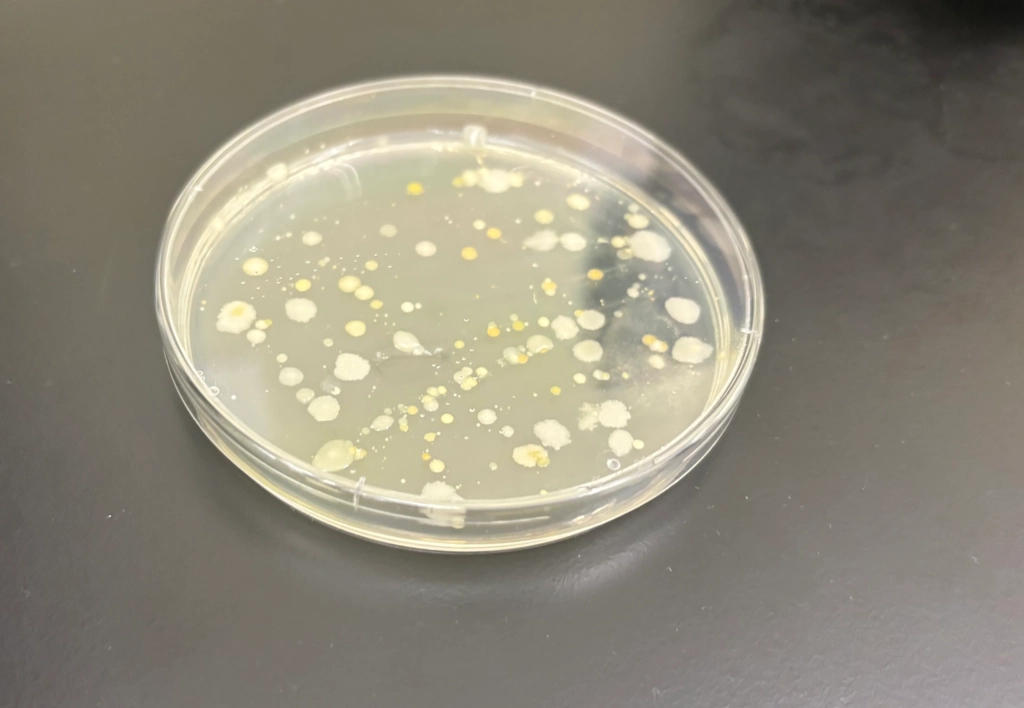
Using Light to Trap my Shoe Bacteria

At UofT, I built implantable devices that got tested in rats at the Franklin Lab and did simulations for novel drug delivery methods at the Miller Lab. I also designed transducers to merge biology and engineered devices at the nanoscale at Berkeley EECS and broke power supplies at MIT.
I finished my Physics and Math degree in 2.5 years, and spent time at Age1, a longevity-focused venture fund.
Before, I was on the business consulting path — I worked at a YC and YC-China company. I was also a profiting Notion Youtuber.
My journey to biotech started when I got into the first cohort of the Dojo House at Boston. Prior, I was selected for a Canadian Space Fellowship, launched one of my designs for the International Space Station on a parabolic flight, was the youngest member on a graduate cube satellite team that launched via SpaceX, and electrocuted mycelium for a NASA NIAC company.
Outside of school, I used to work at a Michelin restaurant.